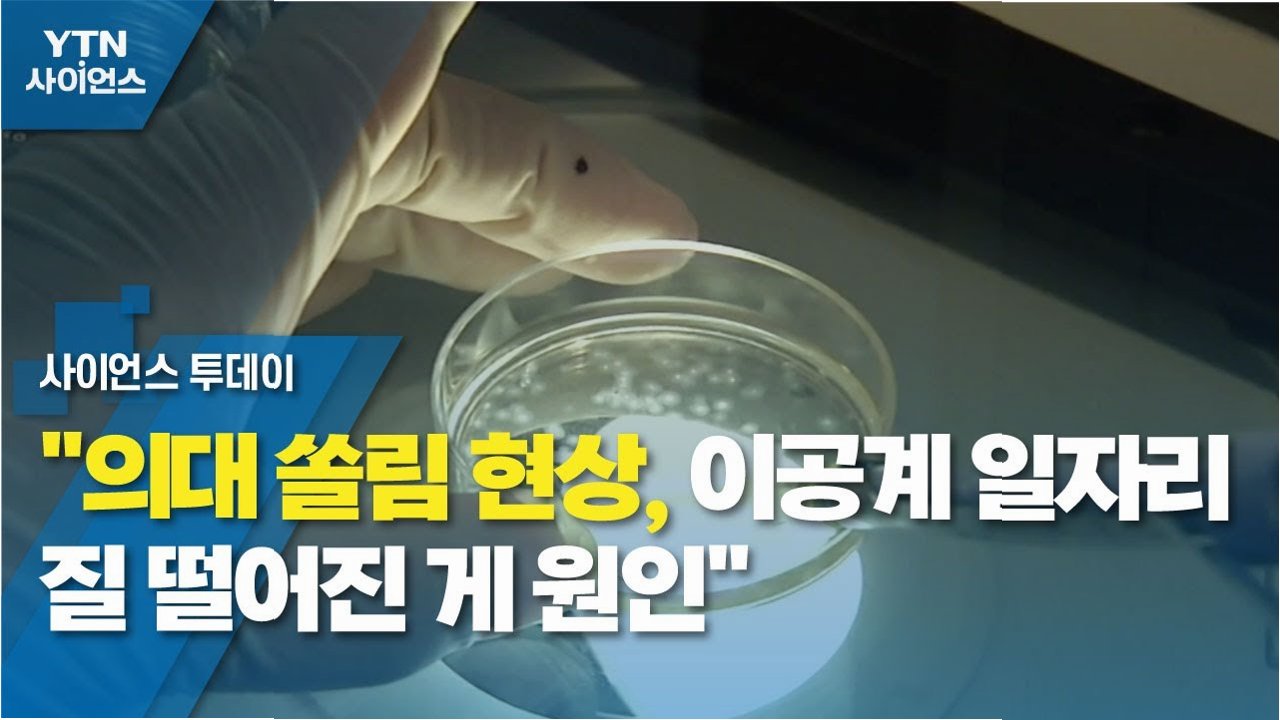

의대, 강남 3구 쏠림 현상 심화… '개천에서 용' 꿈은 어디로?
강남 3구, 의대 신입생을 점령하다
최근 발표된 자료에 따르면, 서울대 의대 신입생 중 강남 3구 소재 고등학교 출신 비율이 상당한 것으로 나타났습니다. 이는 교육의 기회 불균형 심화와 사회적 다양성 감소에 대한 우려를 자아내고 있습니다. 특히, 서울대 의대 신입생 5명 중 1명, 고려대 의대 신입생 4명 중 1명이 강남 3구 고교 출신이라는 사실은 주목할 만합니다. 이러한 현상은 단순한 통계를 넘어, 우리 사회의 교육 시스템과 계층 이동의 현실을 보여주는 지표로 작용합니다.
의대별 강남 3구 출신 비율, 격차는 얼마나?
서울대 의대 신입생 중 강남 3구 고교 출신 비율은 21.9%로, 다른 학과에 비해 높은 수치를 기록했습니다. 고려대 의대 역시 24.78%로, 4명 중 1명꼴로 강남 3구 출신 학생이었습니다. 한양대 의대는 31.82%로, 가장 높은 비율을 보였습니다. 이는 2023년과 작년에도 비슷한 경향을 보이며, 특정 지역 출신 학생들의 의대 진학 쏠림 현상이 지속되고 있음을 시사합니다. 이러한 쏠림 현상은 교육 기회의 불균형을 심화시키고, 사회적 다양성을 저해하는 요인으로 작용할 수 있습니다.

전국 의대, 강남 3구 출신 비율은?
전국 38개 의대 중 자료를 제출하지 않은 1곳을 제외한 37곳을 살펴보면, 강남 3구 출신 신입생 비율이 0~10%인 곳이 19곳으로 가장 많았습니다. 10~20%는 10곳, 20~30%는 8곳, 30% 이상은 1곳이었습니다. 강남 3구 출신 신입생 비율이 가장 낮은 곳은 전남대로, 3.03%를 기록했습니다. 이러한 분포는 의대 간에도 출신 배경의 다양성이 존재하며, 지역별 교육 환경의 차이를 반영한다는 것을 보여줍니다.

교육 불균형 심화, 사회적 해법은?
더불어민주당 김문수 의원은 “교육의 계층과 지역 쏠림이 우려된다”며, “과도한 쏠림은 학생에게는 지나친 경쟁을, 가정에는 높은 사교육비 부담을 초래하는 만큼 균형과 다양성을 높일 해법을 찾아야 한다”고 강조했습니다. 이는 단순한 통계 분석을 넘어, 사회 전체가 함께 고민하고 해결해야 할 과제임을 시사합니다. 교육 시스템의 공정성을 확보하고, 다양한 배경을 가진 학생들이 동등한 기회를 가질 수 있도록 제도적 개선이 필요합니다.

교육 불균형 심화, 사회적 해법은?
김 의원은 교육의 계층과 지역 쏠림 현상에 대한 우려를 표명하며, 균형과 다양성을 높이기 위한 해법 마련을 촉구했습니다. 이는 단순한 통계 분석을 넘어, 사회 전체가 함께 고민하고 해결해야 할 과제임을 시사합니다. 교육 시스템의 공정성을 확보하고, 다양한 배경을 가진 학생들이 동등한 기회를 가질 수 있도록 제도적 개선이 필요합니다. 교육 불균형 문제는 개인의 노력만으로 해결될 수 없는 사회 구조적인 문제입니다. 따라서, 정부, 교육계, 학부모, 학생 등 모든 구성원이 함께 노력하여, 교육의 기회 균등을 실현해야 합니다.

핵심 요약: 의대 쏠림 현상, 교육 불균형 심화, 그리고 해결 과제
서울대, 고려대, 한양대 의대를 중심으로, 강남 3구 출신 신입생 쏠림 현상이 두드러지고 있습니다. 이는 교육 기회의 불균형 심화와 사회적 다양성 감소를 초래하며, 교육 시스템의 공정성 확보와 제도적 개선이 시급함을 보여줍니다. 균형과 다양성을 높이는 해법 마련을 통해, 모든 학생에게 동등한 기회를 제공해야 합니다.

자주 묻는 질문 (FAQ)
Q.강남 3구 출신 학생들의 의대 진학률이 높은 이유는 무엇일까요?
A.강남 3구는 교육 인프라가 잘 갖춰져 있고, 사교육 시장이 발달하여, 학생들이 의대 진학에 유리한 환경에 놓여있기 때문으로 분석됩니다.
Q.이러한 쏠림 현상이 사회에 미치는 영향은 무엇인가요?
A.교육 불균형 심화, 사회적 다양성 감소, 계층 이동의 어려움 등을 초래할 수 있습니다. 이는 사회 통합을 저해하고, 미래 사회의 발전을 저해하는 요인으로 작용할 수 있습니다.
Q.어떻게 하면 교육 기회의 불균형을 해소할 수 있을까요?
A.교육 시스템의 공정성을 강화하고, 지역별 교육 격차를 해소하며, 다양한 배경을 가진 학생들에게 동등한 기회를 제공하는 정책 마련이 필요합니다. 또한, 사회 구성원 모두가 교육의 중요성을 인식하고, 함께 노력하는 자세가 중요합니다.
